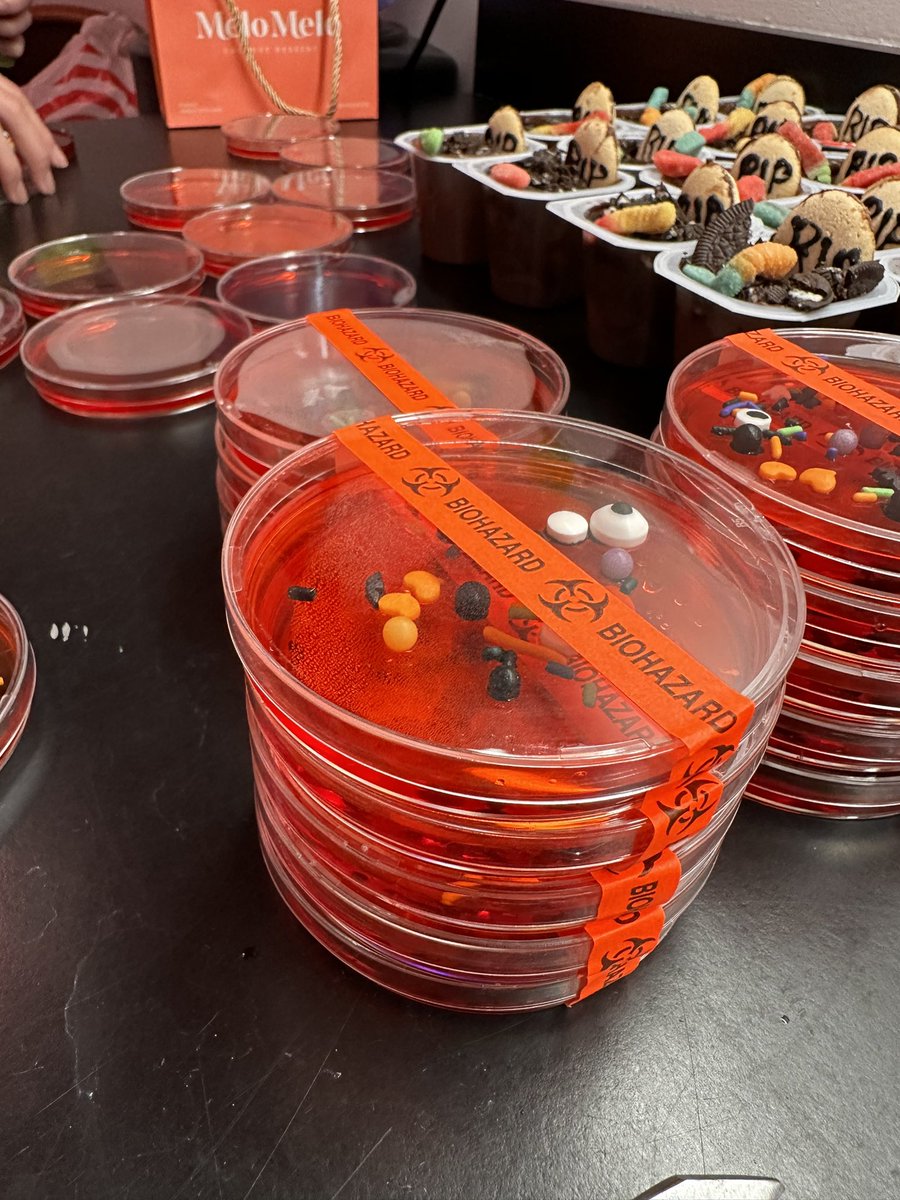
Thomas P200 Burke tweet media

Sabitlenmiş Tweet
Thomas P200 Burke
1.4K posts

Thomas P200 Burke
@FindMeInTheLab
Asst Prof at UC Irvine School of Medicine 🧫 bacterial pathogenesis, microbial cancer therapies ☀️ (Gram) positive vibes only
Katılım Mayıs 2016
663 Takip Edilen1.2K Takipçiler

This will be my final post on this app.
It was a fun ride for our scientific community while it lasted, but I'm happy to see that folks are making the shift to the Blue place. Find me there at @findmeinthelab.bsky.social
English
Thomas P200 Burke retweetledi

The latest from the Stetson lab! A new IFNb-reporter mouse to study type I IFN regulation. Check it out:
journals.aai.org/jimmunol/artic…
English

@FindMeInTheLab Customized coffee cups. Title/author list on one side, a key figure on the other. I give one to a trainee for their 1st 1st-authored paper. Get one for yourself, too, since this one is special.
About $15 from Vistaprint

English

@FindMeInTheLab Contrats @FindMeInTheLab !
Cupcakes? Beer? Champagne? Miller High Life (the champagne or beers)? Bounce house for the lab?
English

Our department Microbiology and Molecular Genetics at @UCIrvine @UCIMedSchool has an open faculty position! RNA biologists and microbiologists studying RNA are encouraged to apply. Come be a part of our vibrant and rapidly growing research community!

Yongsheng Shi@YongshengShi
My department is hiring a tenure-track faculty focusing on RNA biology! @UCIrvine has a large, vibrant and super supportive RNA community! Come join us! recruit.ap.uci.edu/JPF09320
English
Thomas P200 Burke retweetledi
Thomas P200 Burke retweetledi

Search: Tenure track Faculty Position @UCSF in the Dept. of Micro and Immuno, with lab space at the Mission Bay campus! We seek a creative investigator with a strong independent research plan who will be a great mentor, colleague, and peer. Job ad soon. Assistant Prof level.
English
Thomas P200 Burke retweetledi

🚨We are hiring!!🚨
@UICMicrobiology has an open faculty search in any area of host-pathogen interactions. Apply by 10/31 to join us in the heart of Chicago! uic.csod.com/ux/ats/careers…

Francis Alonzo@FrancisAlonzo12
As a former trainee and current member of the faculty, I can say @UICMicrobiology is a great place to study host-pathogen interactions! Apply for our open faculty position! @thisisUIC @uiccom uic.csod.com/ux/ats/careers…
English

Wow, congrats to Profs Phil Felgner, Lisa Wagar @lisa_wagar , Matt Marsden and the other @UCIMedSchool faculty on their $33 million (!!) grant from NIAID on pandemic preparedness - big things to come!
English

@lightsam1 Wow this is embarrassing Sam. However I applaud your totally independent and self-motivated conviction to tell the world about your horribleness.
English
Thomas P200 Burke retweetledi

In case anyone forgot, I came in last place last season in fantasy football. Per Portnoy league bylaws, here is my mandated public acknowledgment: I’m terrible at fantasy football. Thanks commish @FindMeInTheLab for the reminder and always maintaining the integrity of league.
English
Thomas P200 Burke retweetledi
Thomas P200 Burke retweetledi

Brat summer is never ending! I’m proud to announce the release of my thesis project on BioRxiv: biorxiv.org/content/10.110…
In this paper, we unravel the mysterious roles of RickA and Sca2 in cell-to-cell spread and pathogensis during infection with R. parkeri.
English

Portnoy labbers past and present along with the man the myth the legend himself #GRCtoxpath!
Congrats to Andrea @lovingbacteria on being selected to chair the next GRS!
@aaronwhiteley @ReniereLab @SauerLab @DrBadBug
English